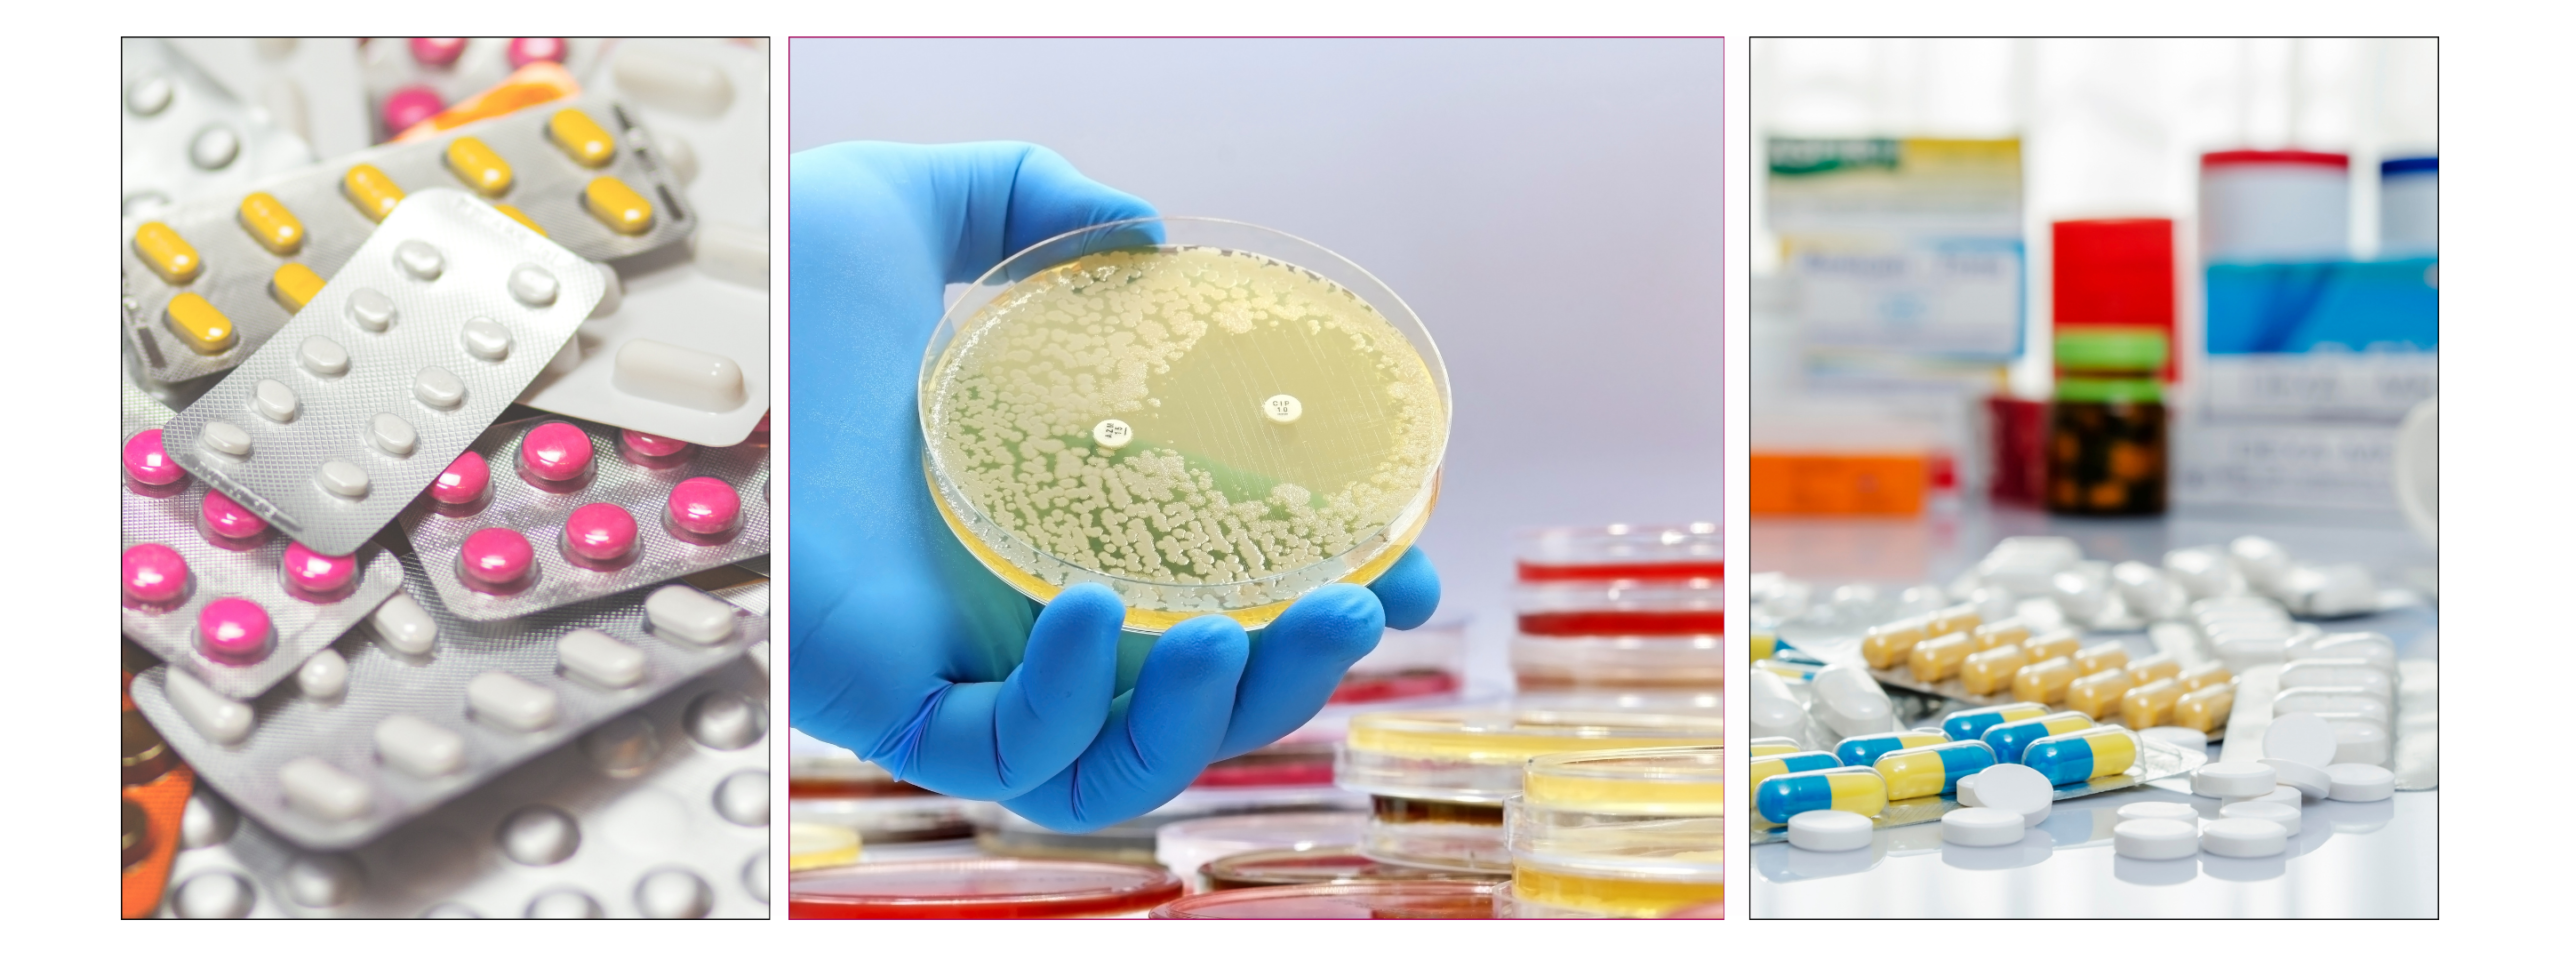
antybiotyk 3 (1)

ANTYBIOTYKI
NIEBEZPIECZENSTWO DLA CZŁOWIEKA – NIE DLA BAKTERII
LEKKOMYŚLNOŚĆ
Na przestrzeni lat lekkomyślnie stosowane antybiotyki nie tylko wyniszczyły bezpowrotnie ludzką symbiotyczną florę bateryjną, ale i sprawiły, że bakterie uodporniły się na ich działanie. Efektem tego jest powstanie coraz to większej ilości szczepów bakterii lekoopornych co oznacza, że medycyna nie posiada środków aby skutecznie leczyć zakażenia tymi patogenami.
Przewlekłe zakażenia bakteriami lekoopornymi z czasem przeradzają się w poważne problemy przewlekłe w wyniku których człowiek zostaje skazany na zażywanie leków steroidowych czyli immunosupresyjnych, czyli osłabiających układ odpornościowy oraz utrzymujących go w ciągłym stanie stresu co wyniszcza trwale nadnercza.
Jednym słowem mówiąc, coś co powstało w celu ratowania życia ludzkiego gdy inne metody zawiodą (bo takie było założenie Fleminga), przez lekkomyślność i nadużycia lekarzy stało się czynnikiem destrukcyjnym dla życia i zdrowia człowieka.
STAN ZAPALNY
Ludzki organizm wytwarza stan zapalny aby się czegoś ze swojego wnętrza pozbyć. Antybiotyk niczego nie leczy. Kiedy zażywasz antybiotyk zabierasz organizmowi jedyne narzędzie walki z toksynami i patogenami jakie posiada czyli stan zapalny.
Antybiotyk ściąga stan zapalny, ale toksyny, metale ciężkie, patogeny, pasożyty i śluz zostają uwięzione w twoim ciele. Za każdym razem.
Pomyśl ile tego nagromadziło się w twoim wnętrzu przez całe życie.
Czas najwyższy przerwać to niekończące się pasmo destrukcji ciał ludzkich i zamiast osłabiać zacząć o odporność dbać i ją stymulować w sposób naturalny.
MASZ WYBÓR
Masz wybór antybiotyk i chemia nie są jedyną terapią. Altaira ma dla ciebie wiedzę o holistyczne terapie naturalne.
BEZ ANTYBIOTYKU
——-
Zadziwiające jest to, że w 90% chorób górnych i dolnych dróg oddechowych możesz uniknąć antybiotyku. Daj więc sobie szansę na naturalny powrót do zdrowia – jeśli natura nie zadziała sięgniesz po antybiotyk, ale najpierw spróbuj czegoś co pomaga 80% ludzi nie doprowadzając ich zdrowia do destrukcji, nie wywołując skutków ubocznych.
Matka natura nie tylko przywróci twoje zdrowie, ale i wzmocni odporność twojego organizmu.
Wiele osób chce leczyć swoje dolegliwości naturalnie, ale nie posiada w tym zakresie wystarczającej wiedzy – właśnie dla nich powstała Wizyta o Wysokim Priorytecie oraz cały zasób wiedzy w poradnikach Altairy.
Podejście naturalne nie wyniszcza twojej flory bakteryjnej oraz nie może ci zaszkodzić ponieważ opiera się o naturalne środki stymulujące twój układ odpornościowy tak aby samodzielnie zwalczył infekcję.

GORĄCZKA
_______
Wielu rodziców panicznie boi się gorączki u swoich dzieci. Gdy tylko temperatura przekracza 37’C natychmiast podają popularne środki przeciwgorączkowe pozbawiając tym samym organizm własnych narzędzi obrony.
Strach przed gorączką jest całkowicie NIEUZASADNIONY.
Gorączka jest naturalnym stanem fizjologicznym organizmu w czasie infekcji. Zależnie od wysokości temperatury ciała organizm uruchamia reakcje biochemiczne będące częścią naszego naturalnego systemu obronnego. Bez gorączki organizm nie może zwalczać wirusów, bakterii a nawet niektórych pasożytów.
Dopiero powyżej 38’C w organizmie zostają wytworzone interferony.
CO TO SĄ INTERFERONY
_______
Interferony to białka sygnałowe należące do tzw. cytokin – czyli cząsteczek, którymi komórki „porozumiewają się” w sytuacji zagrożenia.
Kiedy organizm je produkuje?
Najczęściej wtedy, gdy wykryje intruza, zwłaszcza:
- wirusy
- niektóre bakterie i pasożyty
- komórki nowotworowe
Już w pierwszych godzinach infekcji zakażone komórki zaczynają je uwalniać, aby ostrzec resztę organizmu. Aby siły obronne organizmu mogły działać musi zostać podniesiona temperatura ciała.
Jaki jest ich cel?
- 🔹 hamują namnażanie wirusów w komórkach
- 🔹 aktywują komórki odpornościowe (np. limfocyty, komórki NK)
- 🔹 zwiększają „czujność” układu immunologicznego
- 🔹 pomagają usuwać zakażone lub uszkodzone komórki
👉 Najprościej mówiąc: interferony są jak system wczesnego alarmu — nie zabijają patogenów bezpośrednio, ale uruchamiają silną reakcję obronną organizmu i przygotowują go do walki.
JEŚLI ZBIJASZ DZIECKU NAWET NAJMNIEJSZĄ TEMPERATURĘ ORGANIZM TRACI NARZĘDZIA DO WALKI Z INFEKCJĄ.
Nie dziw się więc, że twoje dzieci ciągle chorują… Odbierając organizmowi narzędzie do walki z patogenami dajesz im doskonałe miejsce do namnażania i infekowania ciała własnego dziecka.
KIEDY GORĄCZKA JEST NIEBEZPIECZNA
_______
Z moich wieloletnich obserwacji wynika, że organizm dziecka i człowieka dorosłego w czasie infekcji podnosi temperaturę do 40’C (czasami 40,5’C) na maksymalnie 3 -4 godziny po czym ją obniża do 38,5″C. Na prawdę wysoka temperatura nigdy nie trwa długo ponieważ organizm ma własny system termoregulacji i nie pozwoli sam sobie zrobić krzywdy.
Najczęściej gorączka przebiega falami od 37’C przez 38’C, które utrzymuje się przez kilka godzin a następnie przechodzi do 40’C, które utrzymują się zaledwie 1-2-3 a czasami 4 godziny a następnie stopniowo spada do stanu podgorączkowego.
Taki stan jest naturalny i fizjologiczny. W czasie gorączki organizm walczy z infekcją a w czasie spadku temperatury daje ciału przestrzeń na nawodnienie i zjedzenie czegoś lekkiego.
Normalne jest utrzymywanie się takiego stanu nawet przez kilka dni. Jeśli pozwolimy dziecku się wychorować i odpowiednio o nie zadbamy będziemy mieli wiele miesięcy spokoju od infekcji.
Oczywiści w każdej chwili możesz z dzieckiem udać się do lekarza. Ja jednak wychowałam się w czasach gdzie nikt nie pędził z dzieckiem na sor z powodu kataru. W czasach mojego dzieciństwa wszyscy wiedzieli, że gorączka jest potrzebna organizmowi do wali. Jeśli termometr pokazywał 40’C mama brała miskę z wodą i robiła zimne okłady na czoło. Kiedy temperatura spadała dawała syrop z cebuli i rosół do picia. Po 3-4 dniach ciało wracało do zdrowia – samo.
Dzieci są w stanie znieść znacznie wyższą temperaturę niż ludzie dorośli a organizm nigdy nie podniesie temperatury tak, aby to jemu zaszkodziło. Organizm sam sobie nigdy nie zrobi krzywdy, ale krzywdę robią mu nieświadomi ludzie.
Dla człowiek dorosłego 40′ to może być dużo. Od 39’C warto robić zimne okłady na czoło i kark , ale na miłość boską – pozwól organizmowi działać! Pozwól sobie być chorym! Odpoczywaj i śpij.
Dzieci są bardziej odporne i dla nich próg temperatury jest wyższy, niektórzy wskazują nawet, że oscyluje w granicach 42’C. Nigdy jednak nie spotkałam się aby temperatura 41’C wzrosła na dłużej niż dwie godziny. Wystarczyły zimne okłady i dobrze poinstruowana mama.
Organizm potrzebuje 4 dni aby zwalczyć infekcję – daj mu ten czas.
Gdy temperatura 40’C utrzymuje się powyżej 3 godzin a ty czujesz się zaniepokojona skonsultuj się z lekarzem lub swoim terapeutą medycyny naturalnej. Pamiętaj jednak, że strach ma zawsze wielkie oczy a kiedy pozwolimy układowi immunologicznemu posprzątać a ciało nam podziękuje.
Objaw, który bezwarunkowo wymaga pomocy medycznej to drgawki oraz utrata przytomności.
Chcesz wiedzieć jak dbać o ciało naturalnie? Czym jest i Jak wzmocnić układ odpornościowy? Jakie zioła stosować w czasie choroby i gorączki? To wszystko i o wiele więcej przedstawiam w poradniku Sekrety Odporności.
W poradniku Apteczka Homeopatyczna przedstawiłam preparaty homeopatyczne na wiele sytuacji zdrowotnych oraz lek złożony, który w niemal każdej infekcji zastępuje mi antybiotyki i leki.
Cała baza poradników działa również przez wyszukiwarkę w sklepie – wystarczy, że wpiszesz objaw a pojawią się powiązane z nim poradniki.

PODZIEL SIĘ ŚWIATŁEM
❤
Podziel się tym wpisem ze swoimi znajomymi na Facebooku lub Instagramie. Stronę możesz udostępnić również przez WhatsApp oraz Messenger. Być może. dzięki Tobie ktoś trafi w miejsce, którego od dawna szukał
_______
Z wyrazami wdzięczności
Marta Banasiak
Altaira
POZNAJ ALTAIRĘ
Znajdziesz tu informacje o platformie oraz możliwościach, które daje. Altaira otwiera dla Ciebie bramy swojego serca.
PRZEWODNIK DLA KOBIET
To miejsce, które wskaże kierunek do zdrowia, każdej otwartej i gotowej na zmiany kobiecie.
PRZEWODNIK PO ODPORNOŚCI
Odnajdziesz tu kierunek, dzięki któremu zrozumiesz potrzeby swojego organizmu.
ODTRUWANIE Z TOKSYN
Odtruwanie organizmu z toksyn i szczepień na poziomie komórkowym to podstawa zdrowia. Nie czekaj – Działaj.




